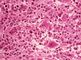

- Забрюшинное пространство
- (spatium retroperitoneale; синоним ретроперитонеальное пространство) — клетчаточное пространство, расположенное между задней частью париетальной брюшины и внутрибрюшной фасцией; простирается от диафрагмы до малого таза
В забрюшинном пространстве находятся почки, надпочечники, мочеточники, поджелудочная железа, нисходящая и горизонтальная части двенадцатиперстной кишки, восходящая и нисходящая ободочная кишка, брюшная часть аорты и нижняя полая вена, корни непарной и полунепарной вен, симпатические стволы, ряд вегетативных нервных сплетений, ветви поясничного сплетения, лимфатические узлы, сосуды и стволы, начало грудного протока и жировая клетчатка, которая заполняет пространство между ними (рис. 1). Сложная система фасциальных пластинок разделяет забрюшинное пространство на ряд отсеков. Вблизи латерального края почки забрюшинная фасция разделяется на два листка — пред- и позадипочечную фасции. Первая соединяется медиально с фасциальными футлярами аорты и нижней полой вены, переходя на противоположную сторону, вторая вплетается в части внутрибрюшной фасции, покрывающие ножку диафрагмы и большую поясничную мышцу. Забрюшинный клетчаточный слой расположен между внутрибрюшной и забрюшинной фасциями. Жировая капсула почки (околопочечная клетчатка, paranephron) лежит между листками забрюшинной фасции, она продолжается по ходу мочеточника. Околокишечная клетчатка (paracolon) находится между задними поверхностями восходящей и нисходящей ободочных кишок и забрюшинной фасцией. Латерально она ограничена сращением последней с париетальной брюшиной, медиально доходит до корня брыжейки тонкой кишки и содержит фиброзные пластинки (фасция Тольдта), сосуды, нервы и лимфатические узлы толстой кишки. Выделяют также непарное срединное пространство, содержащее замкнутые в своих фасциальных футлярах брюшную часть аорты, нижнюю полую вену, расположенные рядом с ними нервы, лимфатические узлы и сосуды.
Методы исследования. Используют клинические методы — осмотр, пальпацию, перкуссию. Обращают внимание на цвет кожи, выпячивания или припухлости, инфильтраты или опухоли брюшной стенки. Наиболее информативной является пальпация брюшной стенки в положении больного на спине с валиком, подложенным под поясничную область. Клиническое обследование позволяет заподозрить гнойно-воспалительное заболевание, кисту или опухоль забрюшинного пространства , а также некоторые заболевания располагающихся в нем органов (см. Аорта, Двенадцатиперстная кишка, Мочеточник, Поджелудочная железа, Почки). Методы рентгенологического исследования, применяемые для диагностики заболеваний забрюшинного пространства , разнообразны: обзорная рентгенография органов грудной и брюшной полостей, рентгеноконтрастное исследование желудка и кишечника, пневмоперитонеум, пневморетроперитонеум, урография, панкреатография, аортография (см. Ангиография), селективная ангиография ветвей брюшной части аорты, кавография, лимфография и др. Среди инструментальных методов исследования ведущую роль в диагностике заболеваний забрюшинного пространства играют ультразвуковое сканирование (см. Ультразвуковая диагностика) и компьютерная рентгеновская томография, которые можно проводить амбулаторно в условиях диагностического центра. Они позволяют установить локализацию патологического очага, его размеры, взаимоотношения с окружающими органами и тканями. Под рентгенотелевизионным контролем возможна диагностическая или лечебная пункция.
Повреждения. Чаще встречается забрюшинная гематома, обусловленная механической травмой. Гематома больших размеров, особенно в первые часы, по клинической симптоматике напоминает повреждение полого или паренхиматозного органа брюшной полости. Острое кровотечение может быть причиной развития геморрагического шока (см. Травматический шок). Выявляются симптомы раздражения брюшины — резкая болезненность и напряжение мышц брюшной стенки, положительный симптом Блюмберга — Щеткина, что позволяет заподозрить развитие перитонита. Однако в отличие от повреждения полых органов брюшной полости, для которых характерно прогрессирование клинических проявлений перитонита, при забрюшинной гематоме они выражены менее ярко и постепенно исчезают. При массивной забрюшинной гематоме нарастает парез желудочно-кишечного тракта, снижается содержание гемоглобина, гематокрита и количества эритроцитов в крови. Ведущая роль в дифференциальной диагностике принадлежит лапароскопии. При больших забрюшинных гематомах кровь может просачиваться в брюшную полость через неповрежденный задний листок брюшины, что затрудняет диагностику. С помощью рентгенологических методов исследования удается обнаружить пневмоперитонеум при повреждении полого органа брюшной полости, а при забрюшинной гематоме — нечеткость контуров и смещение почки, поясничной мышцы, мочевого пузыря, забрюшинных отделов кишечника. Более полную и точную информацию получают при ультразвуковом исследовании и компьютерной рентгеновской томографии.
Лечение повреждений забрюшинного пространства проводят в стационаре. В отдельных случаях, при отсутствии признаков кровотечения, повреждения органов брюшной полости и изменений со стороны крови и мочи, возможно амбулаторное лечение с обязательным ежедневным контролем состояния пострадавшего в течение 2—3 дней после травмы. Лечение изолированных забрюшинных гематом без повреждения органов забрюшинного пространства — консервативное и включает комплекс мероприятий, направленных на борьбу с шоком, кровопотерей и парезом желудочно-кишечного тракта. При продолжающемся внутреннем кровотечении или выявлении признаков повреждения органов забрюшинного пространства (почки, поджелудочной железы, крупных сосудов) показано экстренное оперативное вмешательство.
Прогноз при изолированных забрюшинных гематомах в большинстве случаев (благоприятный, если не происходит инфицирования.
Заболевания. Гнойно-воспалительные процессы в забрюшинной клетчатке могут иметь серозный, гнойный и гнилостный характер. В зависимости от локализации поражения различают паранефрит, параколит (см. Кишечник) и воспаление собственно забрюшинной клетчатки. Клиническая картина гнойно-воспалительных процессов забрюшинного пространства складывается из признаков общей интоксикации (озноб, высокая температура тела, анорексия, слабость, апатия, лейкоцитоз и сдвиг лейкоцитарной формулы крови влево, в тяжелых случаях прогрессирующие нарушения функции сердечно-сосудистой системы и др.). Одновременно выявляют изменение контуров или выбухание брюшной стенки в поясничных или эпигастральной областях, образование инфильтрата, мышечное напряжение и др. Забрюшинный абсцесс часто сопровождается сгибательной контрактурой в тазобедренном суставе на стороне поражения. Тяжелыми осложнениями гнойно-воспалительных процессов забрюшинного пространства являются прорыв забрюшинного абсцесса в брюшную полость с последующим развитием перитонита, распространение забрюшинной флегмоны в средостение, возникновение вторичного остеомиелита костей таза или ребер, кишечных свищей, парапроктита, гнойных затеков в ягодичную область, на бедро. Диагноз гнойно-воспалительного процесса ставят на основании клинической картины, а также данных ультразвукового и рентгенологического исследований. Лечение воспалительных процессов забрюшинного пространства при отсутствии признаков нагноения консервативное (антибактериальная, дезинтоксикационная и иммуностимулирующая терапия). При формировании флегмоны или абсцесса показаны их вскрытие и дренирование. В результате перенесенного гнойно-воспалительного процесса забрюшинного пространства может развиться ретроперитонеальный фиброз (см. Ормонда болезнь).
Опухоли забрюшинного пространства возникают из тканей расположенных в нем органов (двенадцатиперстной кишки, мочеточника, почки и др.) и неорганных тканей (жировой клетчатки, мышц, фасций, сосудов, нервов, симпатических нервных узлов, лимфатических узлов и сосудов). По гистогенезу выделяют опухоли мезенхимального происхождения (мезенхимомы, липомы, липосаркомы, лимфосаркомы, фибромы, фибросаркомы и др.), нейрогенного (неврилеммомы, нейрофибромы, параганглиомы, нейробластомы и др.), тератомы и др. (рис. 2—8). Различают доброкачественные и злокачественные, одиночные и множественные забрюшинные опухоли.
Ранние симптомы при забрюшинных опухолях обычно отсутствуют. Постепенно опухоль достигает больших размеров, смещая соседние органы. Больные ощущают дискомфорт в брюшной полости, ноющие боли в животе и пояснице. Иногда опухоль обнаруживается случайно при пальпации живота, появлении чувства тяжести в животе, обусловленного опухолью, или при нарушении функции кишечника, почек (непроходимости кишечника, почечной недостаточности) и др.
При обширных забрюшинных опухолях нарушается венозный и лимфатический отток, что сопровождается отеком и венозным застоем в нижних конечностях, а также асцитом, расширением подкожных вен живота. В отличие от злокачественных доброкачественные опухоли забрюшинного пространства , даже крупные, мало влияют на общее состояние больного, однако при продолжающемся росте могут нарушать функцию соседних органов.
Для уточнения диагноза выполняют рентгенологическое, ультразвуковое исследования и пункционную биопсию. Дифференциальный диагноз проводят с органными забрюшинными опухолями (почек, надпочечников), некоторыми внутрибрюшными опухолями (брыжейки кишечника, яичника), с забрюшинными абсцессом или гематомой, натечником, аневризмой брюшной части аорты.
Лечение в большинстве случаев оперативное. Некоторые виды сарком поддаются химиотерапии, лучевому или комбинированному лечению. Прогноз неудовлетворительный. Для забрюшинных опухолей, особенно сарком, характерно частое рецидивирование.
Операции. Основным оперативным доступом в забрюшинное пространство является люмботомия — внебрюшинное проникновение в забрюшинное пространство через разрез в поясничной области (рис. 9). В ряде случаев, например при операциях на брюшной аорте, применяют чрезбрюшинный доступ, при котором забрюшинное пространство вскрывают после лапаротомии путем рассечения заднего листка париетальной брюшины. Операции, проводимые на органах забрюшинного пространства , описаны в посвященных им статьях, например Поджелудочная железа, Почки.
Библиогр.: Дурнов Л.А., Бухны А.Ф. и Лебедев В.И. Опухоли забрюшинного пространства и брюшной полости у детей, М., 1972; Клиническая онкология, под ред. Н.Н. Блохина и Б.Е. Петерсона, т. 2, с. 340, М., 1979; Клиническая хирургия, под ред. Ю.М. Панцырева, с. 414, М., 1988; Оперативная урология, под ред. Н.А. Лопаткина и И.П. Шевцова, с. 116, Л., 1986; Хегглин Ю. Хирургическое обследование, пер. с нем., с. 189, М., 1980; Хирургическая анатомия живота, под ред. А.Н. Максименкова, с. 632, Л., 1972; Черкес В.Л., Ковалевский Е.О. и Соловьев Ю.Н. Внеорганные забрюшинные опухоли, М., 1976.